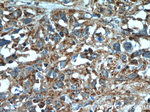
SGK3 Antibody in Immunohistochemistry (Paraffin) (IHC (P))

Search
Proteintech
SGK3 Polyclonal Antibody
{{$productOrderCtrl.translations['antibody.pdp.commerceCard.promotion.promotions']}}
{{$productOrderCtrl.translations['antibody.pdp.commerceCard.promotion.viewpromo']}}
{{$productOrderCtrl.translations['antibody.pdp.commerceCard.promotion.promocode']}}: {{promo.promoCode}} {{promo.promoTitle}} {{promo.promoDescription}}. {{$productOrderCtrl.translations['antibody.pdp.commerceCard.promotion.learnmore']}}
产品信息
12699-1-AP
种属反应
宿主/亚型
分类
类型
抗原
偶联物
形式
浓度
规格
纯化类型
保存液
内含物
保存条件
运输条件
产品详细信息
Immunogen sequence: TDFDFLKVI GKGSFGKVLL AKRKLDGKFY AVKVLQKKIV LNRKEQKHIM AERNVLLKNV KHPFLVGLHY SFQTTEKLYF VLDFVNGGEL FFHLQRERSF PEHRARFYAA EIASALGYLH SIKIVYRDLK PENILLDSVG HVVLTDFGLC KEGIAISDTT TTFCGTPEYL APEVIRKQPY DNTVDWWCLG AVLYEMLYGL PPFYCRDVAE MYDNILHKPL SLRPGVSLTA WSILEELLEK DRQNRLGAKE DFLEIQNHPF FESLSWADLV QKKIPPPFNP NVAGPDDIRN FDTAFTEETV PYSVCVSSDY SIVNASVLEA DDAFVGFSYA PPSEDLFL (160-496 aa encoded by BC015326)
靶标信息
SGKL (SGK3) is a serine/threonine protein kinase which is similar to serum- and glucocorticoid-induced protein kinase (SGK). Unlike SGK, SGKL is not induced by serum or glucocorticoids. It is induced in response to signals that activate phosphatidylinositol 3-kinase, which is also true for SGK. The protein phosphorylates several target proteins and has a role in neutral amino acid transport and activation of potassium and chloride channels. Alternate transcriptional splice variants, encoding different isoforms, have been characterized.
仅用于科研。不用于诊断过程。未经明确授权不得转售。
生物信息学
蛋白别名: Cytokine-independent survival kinase; DKFZp781N0293; Serine/threonine-protein kinase Sgk3; serum/glucocorticoid regulated kinase 3; Serum/glucocorticoid-regulated kinase 3; Serum/glucocorticoid-regulated kinase-like; SGKL; similar to serine-threonine protein kinase; unnamed protein product
基因别名: 2510015P22Rik; A330005P07Rik; CISK; fy; fz; SGK2; SGK3; SGKL
UniProt ID: (Human) Q96BR1, (Mouse) Q9ERE3
Entrez Gene ID: (Human) 23678, (Mouse) 170755, (Rat) 171498